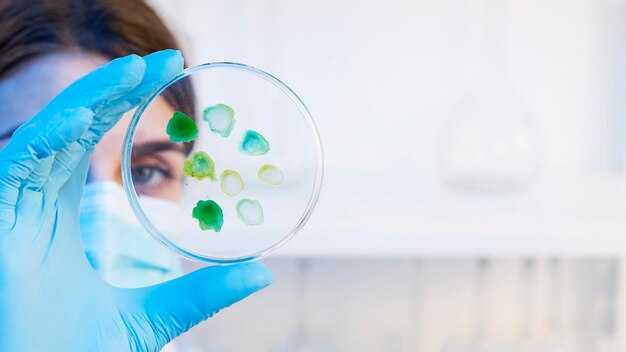
Определение микробиологии и её роль в науке

Как называется наука о бактериях
Специалисты, изучающие одноклеточные организмы, занимаются различными аспектами их жизнедеятельности. Эта дисциплина охватывает такие темы, как классификация, метаболизм, взаимодействие с окружающей средой и роль в экосистемах. Основное внимание уделяется исследованию патогенов, размножению и устойчивости к антибиотикам.
Для глубокого понимания микробной жизни необходимо осваивать множество методик, включая молекулярную биологию, генетические исследования и секвенирование ДНК. Эти инструменты позволяют ученым обнаруживать новые виды и изучать их поведение, что важно для медицины и сельского хозяйства.
Существуют многочисленные направления, которые могут стать интересными для изучения, например, экология микробов, биохимия и биотехнологии. Каждый из этих аспектов помогает разработать новые методы борьбы с инфекциями и других заболеваний, а также использовать микроорганизмы в различных отраслях, от пищевой до фармацевтической.
Определение микробиологии и её роль в науке
Микробиология изучает микроорганизмы, включая вирусы, бактерии, грибы и простейшие. Эта область знаний играет ключевую роль в медицине, агрономии, экологии и производства.
Фундаментальные аспекты её работы включают:
- Изучение патогенов для разработки эффективных методов лечения заболеваний.
- Исследование симбиотических отношений между микроорганизмами и высшими организмами, что позволяет улучшить урожайность растений.
- Разработка биотехнологий для создания новых продуктов, таких как вакцины и антибиотики.
Актуальные достижения в микробиологии:
- Геномные исследования, которые помогают выявить штаммы микроорганизмов с особыми свойствами.
- Применение метагеномики для изучения микробиомов, влияющих на здоровье человека.
- Альтернативные методы борьбы с инфекциями, включая фаготерапию.
Инсайты в эту сферу важны для решения актуальных задач современности, от борьбы с антибиотикорезистентностью до улучшения экосистем. Чтобы углубить знания, рекомендуется участие в конференциях и семинарах, а также чтение специализированной литературы.
Классификация бактерий: основные группы и их особенности
Вторая группа – граммотрицательные микроорганизмы, обладающие тонкой клеточной стенкой и второй мембраной. Они плохо удерживают красители и часто обладают устойчивостью к антибиотикам. К числу значимых представителей относятся Escherichia coli и Salmonella.
Также выделяются аэробные и анаэробные формы. Аэробные организмы требуют кислорода для роста, в то время как анаэробы могут обходиться без него, производя энергетические процессы в бескислородной среде. Примеры анаэробов – Clostridium и Bacteroides.
Реже встречаются микоплазмы – безклеточные микроорганизмы, не имеющие клеточной стенки. Они могут вызывать заболевания дыхательных путей и урогенитальной системы, как, например, Mycoplasma pneumoniae.
На основе метаболических путей также осуществляется классификация. Хемогетеротрофные организмы используют органические вещества как источники углерода, в то время как автотрофы синтезируют углеродные соединения из неорганических источников, таких как углекислый газ. Примером последних являются цианобактерии.
Другая категория – споровые микроорганизмы. Эти виды, как Bacillus и Clostridium, способны образовывать спор, что обеспечивает им выживаемость в неблагоприятных условиях. Споры могут сохраняться в окружающей среде на протяжении многих лет.
При классификации учитывают и форму клеток: кокки (круглые), бациллы (палочковидные) и спирали. Каждая форма характеризуется своими патогенетическими особенностями и реакцией на внешние факторы.
Таким образом, многогранность представленных групп позволяет глубже разобраться в особенностях каждого вида и использовать эти знания для диагностики и лечения инфекционных заболеваний.
Методы изучения бактерий: микроскопия и культурные техники
Второе направление – это культурные методы. Здесь выделяют несколько подходов для выделения и идентификации. Наиболее распространены агаровые и жидкие среды. Необходимо подбирать состав в зависимости от требуемых условий для роста.
Использование селективных сред позволяет изолировать конкретные виды, что может быть полезно для диагностики заболеваний. Примером является среда Сабауро для грибов и среда МакКонки для эшерихий.
| Метод | Описание | Применение |
|---|---|---|
| Оптическая микроскопия | Визуализация микроорганизмов при увеличении | Изучение морфологии |
| Селективные среды | Специально подготовленные среды для изоляции определенных видов | Диагностика инфекций |
| Agar и жидкие среды | Различные составы для стимуляции роста | Культивирование образцов |
Объединение этих методов оптимизирует процесс изучения микробов, позволяя получать более полные данные о их свойствах и поведении.
Роль бактерий в экосистеме: от разложения до симбиоза

Разложение органических веществ – одна из главных функций микробов, способствующих утилизации мёртвой биомассы. Они расщепляют сложные молекулы, превращая их в простые соединения, что обеспечивает возвращение питательных веществ в почву. Без этой активности экосистемы были бы переполнены органическими отходами, затрудняющими жизнь других организмов.
Симбиотические отношения с высшими растениями выделяют еще одну значимую функцию. Некоторые микроорганизмы, такие как нодулярные формы, обеспечивают растения азотом, что способствует их росту. Этот симбиоз содействует увеличению урожайности и разнообразия экосистем.
Микробы также участвуют в процессе минерализации, преобразуя органические формы фосфора, калия и других элементов в доступные для растений формы. Это прямым образом влияет на плодородие почвы и ее способность поддерживать жизнь.
Кроме того, бактерии помогают в биоремедиации, устраняя загрязнители из окружающей среды. Они способны разлагать токсичные соединения, что особенно важно для восстановления экосистем после загрязнений.
Наконец, взаимодействие микроорганизмов с животными в пищевых цепях также заслуживает внимания: они становятся частью микробиота кишечника, способствуя пищеварению и синтезу витаминов, что в свою очередь поддерживает здоровье организмов.
Бактерии и здоровье человека: как они влияют на микрофлору
Поддержание баланса микробов в организме должно быть приоритетом для каждого. Разнообразие микроорганизмов способствует оптимальному функционированию желудочно-кишечного тракта и иммунной системы. Пробиотические продукты, такие как йогурт и квашеная капуста, помогают укрепить полезные формы, которые противостоят болезнетворным агента.
Снижение потребления сахара и переработанных продуктов предотвращает рост патогенных видов, которые могут вызвать дисбаланс. Продукты, богатые клетчаткой, такие как овощи, злаки и бобовые, питают хорошие организмы, способствуя их размножению.
Регулярные физические нагрузки также положительно сказываются на состоянии внутренней флоры. Умеренная активность поддерживает циркуляцию крови и улучшает обмен веществ, что благоприятно для микробной среды. Важно учитывать, что стресс негативно влияет на микрофлору, потому что он способствует воспалительным процессам в организме.
Общие рекомендации включают улучшение режимов сна и использование методов релаксации. Это помогает восстановить внутренние процессы, что в свою очередь положительно сказывается на составе полезных форм. Пробуйте разнообразить рацион и не забывайте о важности воды для поддержания гидратации клеток.
Такая забота о внутреннем мире будет способствовать общему улучшению самочувствия и снижению риска многих заболеваний. Интеграция этих принципов в повседневную практику поможет поддерживать здоровье на высоком уровне. Тщательный подход к питанию и образу жизни формирует крепкий фундамент для полноценной жизни.
Антибиотики и устойчивость бактерий: что необходимо знать

При использовании антибиотиков важно следовать строгим рекомендациям по их применению. Чтобы избежать развития резистентности, рекомендуется:
- Соблюдать предписанную длительность курса лечения. Не прекращать прием препарата до назначения врача.
- Не использовать антибиотики без медицинских показаний. Неправильное применение приводит к устойчивости микроорганизмов.
- Соблюдать дозировку. Избыточное или недостаточное количество препарата снижает его эффективность и способствует росту резистентных форм.
- Не делиться антибиотиками с другими лицами. Каждый случай индивидуален, и неправильное использование может повлечь негативные последствия.
- Обсуждать с врачом возможность альтернативного лечения в случаях, когда применение антибактериальных средств нецелесообразно.
Данные Всемирной организации здравоохранения подтверждают, что резистентные штаммы становятся серьезной угрозой для здоровья населения. Почти 700 тысяч людей ежегодно умирают из-за инфекций, вызванных устойчивыми к лечению формами. Прогнозируется увеличение этой цифры до 10 миллионов к 2050 году, если не предпринять необходимые меры.
Для снижения риска резистентности необходимо:
- Участвовать в вакцинации, что позволяет предотвратить развитие инфекций и, как следствие, использование антибиотиков.
- Соблюдать гигиену, чтобы снизить вероятность инфекционных заболеваний.
- Сообщать врачам о любых ранее перенесенных инфекциях и лечениях, что поможет в выборе правильной терапии.
Систематическое обучение медицинских работников и общества о правильном использовании антибактериальных препаратов также играет ключевую роль в борьбе с резистентностью. Прозорливый подход к лечению инфекций гарантирует улучшение здоровья и снижение страдания от инфекционных заболеваний.
Практическое применение бактерий в сельском хозяйстве
Используйте меры, основанные на микробиологии, для повышения урожайности и устойчивости культур.
Симбиотические организмы, такие как Rhizobium, обеспечивают азот связанными с корнями растений, тем самым улучшая их развитие. Применение фиксирующих азот бактерий позволяет сократить использование синтетических удобрений, что экономит средства.
Актиномицеты, присутствующие в почве, способствуют разложению органических остатков, освобождая полезные питательные вещества для растений. Регулярное внесение компоста, содержащего эти микроорганизмы, способствует улучшению структуры почвы и увеличивает её плодородие.
Микробные препараты, содержащие Bacillus thuringiensis, могут служить биопестицидом против вредителей. Они воздействуют на личинок насекомых, уменьшая необходимость в химических средствах защиты. Это способствует экологической безопасности сельского хозяйства.
Использование препаратов с Lactobacillus для ферментации органических отходов превращает их в питательное удобрение, которое комплексно обогащает землю микроэлементами и улучшает её общий состав.
Стимуляторы роста на основе бактерий, такие как Pseudomonas fluorescens, повышают устойчивость культур к стрессам, например, засухе или болезням. Это требует более широкого внедрения в практику, чтобы обеспечить стабильность урожая в условиях изменчивого климата.
Семена, обработанные биопрепаратами, содержащими активные микроорганизмы, показывают более высокую всхожесть и стойкость во время прорастания, что также значительно увеличивает вероятность успешного урожая.
Бактерии в производстве продуктов: йогурт и сыр
Для получения йогурта и сыра используют молочнокислые микроорганизмы, такие как Lactobacillus bulgaricus и
При изготовлении йогурта рекомендовано поддерживать оптимальную температуру в диапазоне 40-45°C в течение 4-8 часов. Это обеспечит активное размножение бактерий и правильное формирование текстуры.
Сыры, такие как чеддер или пармезан, требуют различных культур, включая Lactococcus lactis и Propionibacterium freudenreichii, что влияет на вкус и зрелость. Для получения полутвердого сыра рекомендуется процесс созревания в контролируемых условиях с соблюдением температурного режима от 10 до 15°C на протяжении нескольких месяцев.
Правильный баланс микроорганизмов не только способствует созданию уникального вкусового профиля, но и увеличивает срок хранения продуктов, что делает их более безопасными для потребления.
Кроме того, использование живых культур в йогурте и сыре поддерживает полезную микрофлору кишечника, что является дополнительным преимуществом для здоровья.
Генетические исследования бактерий: CRISPR и другие технологии

Специалисты рекомендуют использовать технологию CRISPR для редактирования генома микроорганизмов. Она позволяет точно вносить изменения в последовательности ДНК, предоставляя возможности для создания штаммов с улучшенными характеристиками, такими как устойчивость к антибиотикам или способность к биосинтезу. Эффективное применение CRISPR требует оптимизации механизмов доставки, таких как векторные системы или наноносители.
Помимо CRISPR, используют метод TALEN (Transcription Activator-Like Effector Nuclease). Этот подход обеспечивает подобную точность редактирования и применяется для создания специфических мутаций в генах. Важно учитывать, что TALEN требует разработки специфичных для каждого гена эффекторов, что может усложнить процесс.
Метод Zinc Finger Nucleases (ZFNs) также находит применение в манипуляциях с генами прокариотов. Этот метод сочетает в себе модифицированные цинковые пальцы для распознавания специфичных последовательностей ДНК и механизм нуклеазы для их разрезания. Главное преимущество заключается в высокой точности и надежности.
Для анализа генетической информации и функционального исследования используются технологии секвенирования, такие как Illumina и Nanopore. Первые обеспечивают высокую пропускную способность и точность, а Nanopore позволяет получать длинные риды, что полезно для изучения сложных геномов.
| Технология | Преимущества | Недостатки |
|---|---|---|
| CRISPR | Точность, возможность мультигенового редактирования | Требует оптимизации доставки |
| TALEN | Высокая точность | Сложность разработки специфичных эффекторов |
| ZFNs | Надежность и точность | Усложненная конструкция |
При проведении генетических коррекций важно соблюдать этические нормы и учитывать возможные последствия для экосистемы. Эффективные подходы к редактированию требуют междисциплинарного сотрудничества между биологами, генетиками и специалистами в области биоинформатики.
Новые направления в микробиологии: синтетическая биология

Синтетическая биология открывает уникальные возможности для манипуляции генетическим материалом. Рекомендуется обратить внимание на применение CRISPR-технологий для редактирования генов различных микроорганизмов, что позволяет создавать штаммы с заданными свойствами.
Разработка биомолекул с заданными функциями становится реальностью. Например, использование генетически модифицированных культур для производства лекарств или биотоплива может снизить затраты и повысить эффективные характеристики. Основное внимание стоит уделять следующим направлениям:
- Проектирование новых метаболических путей для улучшения продуктивности в производстве биоактивных соединений.
- Создание биосенсоров на основе синтетических организмов для детекции загрязнителей в окружающей среде.
- Разработка ‘умных’ микроорганизмов для применения в агрономии, что позволяет повысить урожайность и устойчивость к болезни.
Также следует обратить внимание на интеграцию синтетической биологии с другими направлениями, такими как биоинформатика и системная биология, что позволит более точно моделировать и предвосхищать реакции микроорганизмов на изменения условий среды.
Инвестирование в инициативы по созданию платформ для обмена данными и ресурсами между исследователями обеспечит синергию и ускорит научные открытия. Эти шаги гарантируют, что синтетическая биология займёт важное место в будущем микробиологии.
Экологическая микробиология: контроль за загрязнением

Для успешного контроля загрязнения окружающей среды применяют методы биоочистки, в которых активно участвуют микроорганизмы. Ферментация биомассы и использование специализированных штаммов позволяют снижать концентрацию токсичных веществ в почве и воде. Например, использование бактерий, способных разлагать нефтепродукты, уже эффективно применяется на загрязненных территориях.
Важно проводить мониторинг состояния экосистем. Регулярный анализ проб воздуха, воды и почвы на наличие патогенных и условно-патогенных представителей может предотвратить потенциальные угрозы. Современные методы молекулярной диагностики, такие как ПЦР, позволяют быстро определить присутствие вредных организмов.
Синергия микробных сообществ может улучшить биодеградацию. Смешивание различных штаммов, обладающих взаимодополняющими функциями, способствует более быстрому разложению загрязняющих веществ. Примером служат комбинации бактерий и грибов, которые способны эффективно очищать почву от пестицидов.
Проведение исследований по всему спектру биоразнообразия в экосистемах помогает определить ключевые микроорганизмы, отвечающие за определенные процессы, такие как разложение органики или участие в круговороте элементов. Эти знания могут быть использованы для разработки адаптивных стратегий управления загрязнением.
Важно также учитывать влияние биоремедиации на экосистему. Восстановление среды обитания и поддержание природных экосистем не менее значимо, чем устранение загрязняющих веществ. Производственные мероприятия должны сопровождаться оценкой воздействия на биоценозы, чтобы сохранить стабильность экосистемы.
Карьера в микробиологии: возможности для специалистов
Работа в научных исследованиях открывает множество перспектив. Исследовательские институты и университеты постоянно ищут научных сотрудников для выполнения проектов, связанных с изучением микроорганизмов и их влияния на здоровье человека и окружающую среду.
Государственные и частные лаборатории предлагают позиции для проведения тестов, анализа проб и разработки новых методик. Заработная плата на таких должностях может варьироваться в зависимости от уровня квалификации и опыта, доход специалистов в этой области часто превышает средние показатели по стране.
Контроль качества в пищевой и медицинской промышленности открывает новые горизонты для микробиологов. Постоянно растёт спрос на специалистов, способных обеспечить безопасность продуктов и диагностических систем.
Область образования также предоставляет возможности для карьерного роста. Преподавание в университетах и колледжах, проведение семинаров и мастер-классов становятся всё более востребованными.
Для успешного построения карьеры стоит вооружиться дополнительными навыками: знание современных технологий анализа данных, умение работать в междисциплинарных командах и грамотная научная коммуникация значительно увеличат шансы на успех в данной сфере.